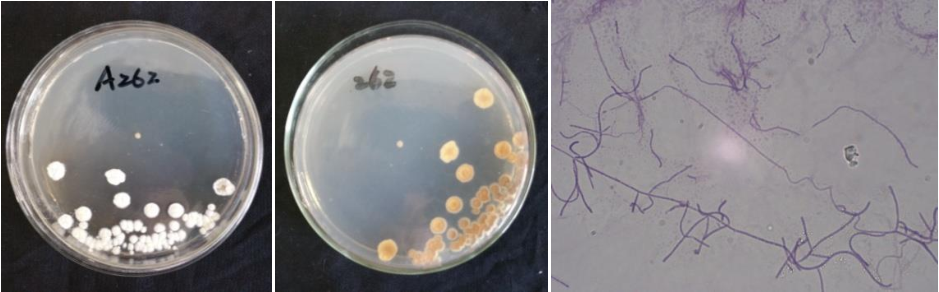

Loading...
| StrainNO | A262 |
| Classification | Streptomyces |
| 16s rDNA sequence | GCATTAACACATGCAAGTCGAACGATGAACCCGCTTCGGTGGGGGATTAGTGGCGAACGGGTGAGTAACACGTGGGCAATCTGC CCTTCACTCTGGGACAAGCCCTGGAAACGGGGTCTAATACCGGATAACACCGGCTCTCGCATGGGAGCTGGTTGAAAGCTCCGG CGGTGAAGGATGAGCCCGCGGCCTATCAGCTTGTTGGTGGGGTGATGGCCTACCAAGGCGACGACGGGTAGCCGGCCTGAGAGG GCGACCGGCCACACTGGGACTGAGACACGGCCCAGACTCCTACGGGAGGCAGCAGTGGGGAATATTGCACAATGGGCGAAAGCC GATGCAGCGACGCCGCGTGAGGGATGACGGCCTTCGGGTTGTAAACCTCTTTCAGCAGGGAAGAAGCGAAAGTGACGGTACCTG CAGAAGAAGCGCCGGCTAACTACGTGCCAGCAGCCGCGGTAATACGTAGGGCGCAAGGCTTGTCCGGAATTATTGGGCGTAAAG AGCTCGTAGGCGGCTTGTCACGTCGGATGTGAAAGCCCGGGGCTTAACCCCGGTCTGCATTCGATACGGGCAGGCTAGAGTGTG GTAGGGGAGATCGGAATTCCTGGTGTAGCGGTGAAATGCGCAGATATCAGGAGGAACACCGGTGGCGAAGGGGATCTCTGGCCA TTACTGACGCTGAGGAGCGAAAGTGGGGGAGCGAACAGGATTAGATACCCTGGTA |
| Strain Morphology Photos | |
| Morphological Description | hyphae:branched without breaking apart;branches:short and thicker;spore filaments:curved;long;and broken into Rod-shaped spores;Spore piles:milky white;back:soybean juice yellow |